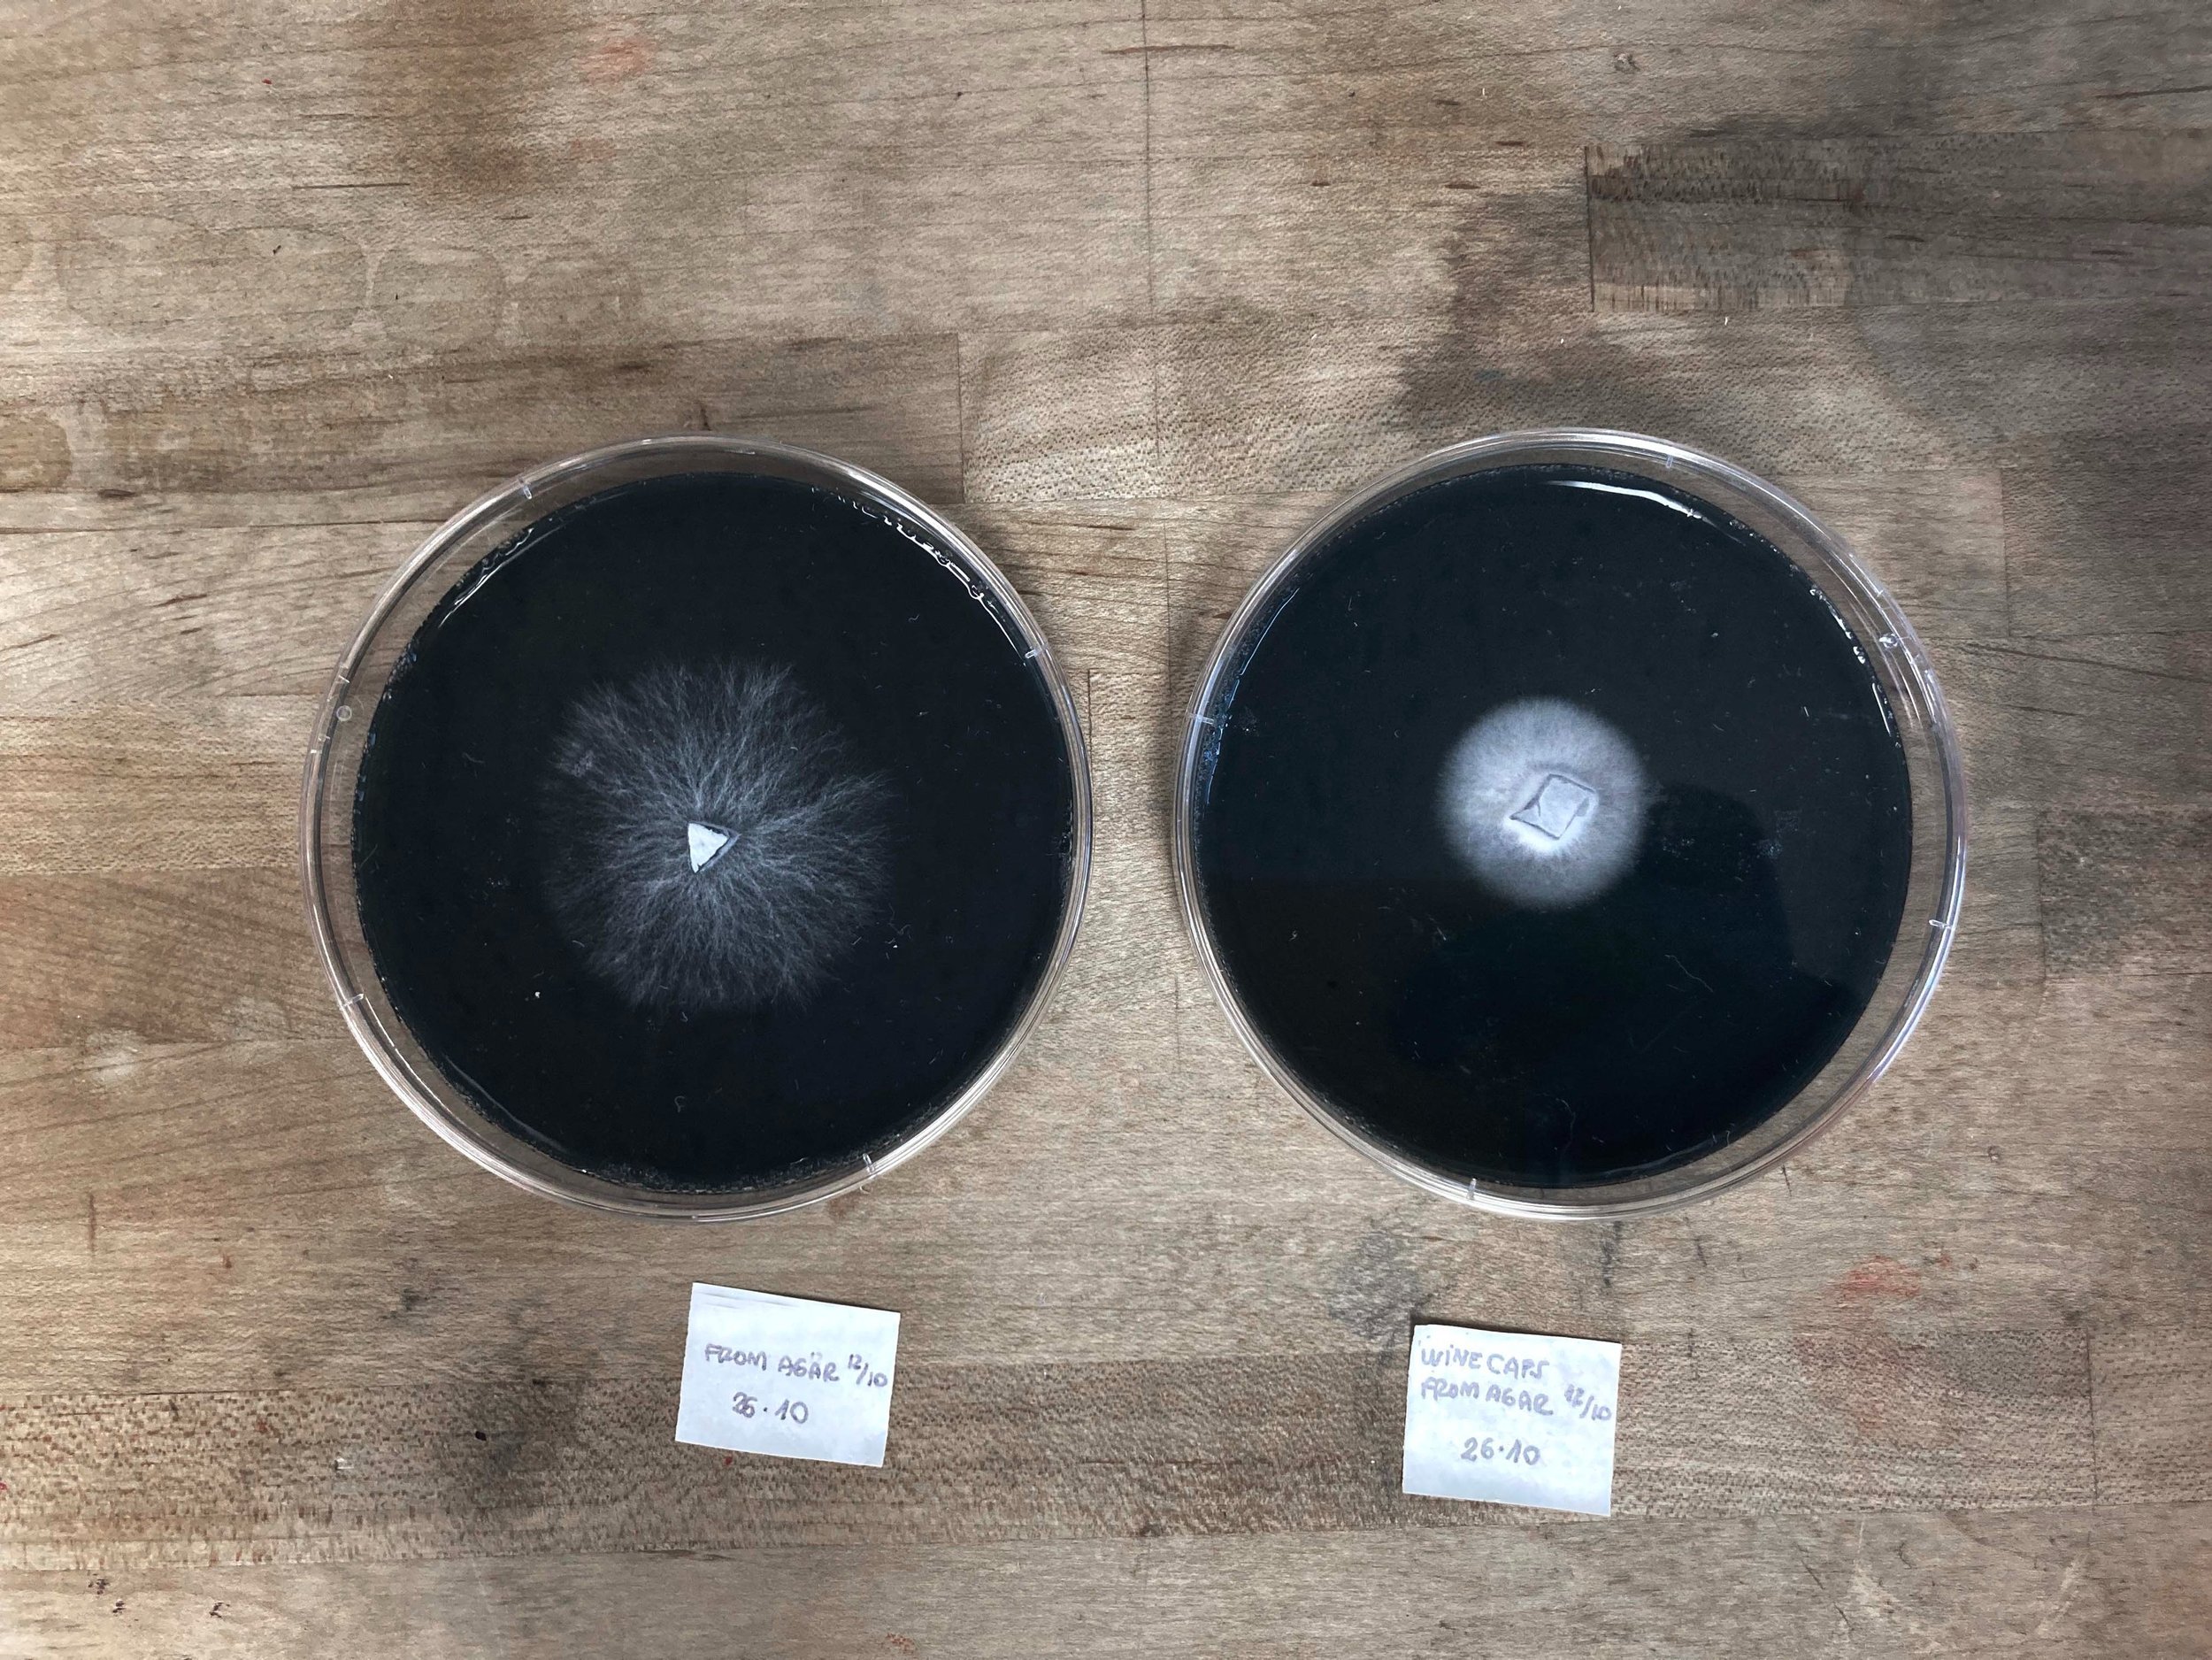

– what if instead of using nature as a resource, we partner up and create together? What if we stop thinking in terms of extraction, consumption, and exploitation and start to wonder about collaboration and symbiosis with non-human others? What possibilities unfold in interspecies creative encounters and what can we learn through them?